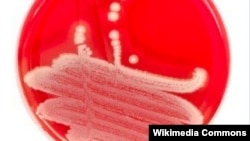
Researchers say anti-bacterial protein, PlyC could be effective antibiotic alternative

SYDNEY — Researchers in Australia say they have made a critical discovery in the search for an alternative to antibiotics. Scientists say it is important to find new ways to treat illnesses without antibiotics, many of which are becoming less effective because microbes are becoming more resistant.
A team at Monash University in Melbourne believes an antibacterial viral protein called PlyC could be used as an alternative to antibiotics.
It was first identified as a possible treatment for infections in 1925 but research was abandoned following the discovery of antibiotics.
After six years studying the structure of the protein with colleagues at the Rockefeller University and University of Maryland, Australian researchers have worked out how it kills the bacteria that cause sore throats, pneumonia and streptococcal toxic shock syndrome.
Dr. Sheena McGowan from Monash University describes the protein as a potent bacterial killing machine that resembles a flying saucer carrying a pair of warheads.
It works by locking onto the surface of the bacterium and then boring though the exterior to destroy it.
McGowan says it could be invaluable when conditions such as pneumonia do not respond to traditional treatments.
“There is antibiotics at the moment for those particular types of diseases. We sort of see that there's a bit of resistance being built up in the bacterial community almost, and some of our antibiotics aren't quite as effective as they used to be," McGowan said. "So this kind of ground route, basic research needs to be done quite early so that we have some time to develop them as safe human therapeutic over the timeframe when the antibiotics can keep working.”
Australian and U.S. researchers have been decoding PlyC's atomic structure, which is an important step in developing the protein into a drug.
The breakthrough has been published in the Proceedings of the National Academy of Science.
An effective human treatment delivered by nasal spray or pill is thought to be at least a decade away, but scientists have had success in treating streptococcal infections in mice.
A team at Monash University in Melbourne believes an antibacterial viral protein called PlyC could be used as an alternative to antibiotics.
It was first identified as a possible treatment for infections in 1925 but research was abandoned following the discovery of antibiotics.
After six years studying the structure of the protein with colleagues at the Rockefeller University and University of Maryland, Australian researchers have worked out how it kills the bacteria that cause sore throats, pneumonia and streptococcal toxic shock syndrome.
Dr. Sheena McGowan from Monash University describes the protein as a potent bacterial killing machine that resembles a flying saucer carrying a pair of warheads.
It works by locking onto the surface of the bacterium and then boring though the exterior to destroy it.
McGowan says it could be invaluable when conditions such as pneumonia do not respond to traditional treatments.
“There is antibiotics at the moment for those particular types of diseases. We sort of see that there's a bit of resistance being built up in the bacterial community almost, and some of our antibiotics aren't quite as effective as they used to be," McGowan said. "So this kind of ground route, basic research needs to be done quite early so that we have some time to develop them as safe human therapeutic over the timeframe when the antibiotics can keep working.”
Australian and U.S. researchers have been decoding PlyC's atomic structure, which is an important step in developing the protein into a drug.
The breakthrough has been published in the Proceedings of the National Academy of Science.
An effective human treatment delivered by nasal spray or pill is thought to be at least a decade away, but scientists have had success in treating streptococcal infections in mice.